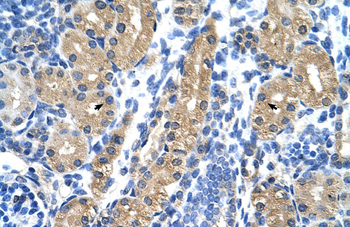
HSD17B1 Rabbit Polyclonal Antibody

You have no items in your shopping cart.
HSD17B1 Rabbit Polyclonal Antibody
Description
Research Area
Images & Validation
−| Tested Applications | ICC, IHC, WB |
|---|---|
| Dilution Range | Western blot, 0.1-0.5μg/ml, Human, Rat Immunohistochemistry (Paraffin-embedded Section), 0.5-1μg/ml, Human, Rat Immunocytochemistry , 0.5-1μg/ml, Human |
| Reactivity | Human, Rat |
Key Properties
−| Antibody Type | Primary Antibody |
|---|---|
| Host | Rabbit |
| Clonality | Polyclonal |
| Isotype | Rabbit IgG |
| Immunogen | A synthetic peptide corresponding to a sequence at the N-terminus of human HSD17B1, different from the related rat and mouse sequences by one amino acid. |
| Target | 17-beta-hydroxysteroid dehydrogenase type 1 |
| Molecular Weight | 37-38 kDa |
| Purification | Immunogen affinity purified. |
| Conjugation | Unconjugated |
Storage & Handling
−| Storage | Maintain refrigerated at 2-8°C for up to 2 weeks. For long term storage store at -20°C in small aliquots to prevent freeze-thaw cycles. |
|---|---|
| Form/Appearance | Lyophilized |
| Buffer/Preservatives | Each vial contains 5mg rAlbumin, 0.9mg NaCl, 0.2mg Na2HPO4, 0.05mg Thimerosal, 0.05mg NaN3. |
| Concentration | Adding 0.2 ml of distilled water will yield a concentration of 500 μg/ml. |
| Expiration Date | 12 months from date of receipt. |
| Disclaimer | For research use only |
Alternative Names
−Similar Products
−HSD17B1 Rabbit Polyclonal Antibody [orb578185]
IHC, WB
Bovine, Canine, Equine, Guinea pig, Porcine, Rabbit, Rat
Human, Mouse
Rabbit
Polyclonal
Unconjugated
100 μlHSD17B1 Rabbit Polyclonal Antibody [orb527012]
ELISA, ICC, IF, IHC, WB
Human
Rabbit
Polyclonal
Unconjugated
100 μgHSD17B1 Rabbit Polyclonal Antibody [orb100743]
WB
Bovine, Canine, Equine, Human, Porcine, Rabbit, Rat
Mouse
Rabbit
Polyclonal
Unconjugated
50 μl, 100 μl, 200 μlHSD17B1 Rabbit Polyclonal Antibody [orb5474]
WB
Bovine, Canine, Equine, Mouse, Porcine, Rabbit, Rat
Human
Rabbit
Polyclonal
Unconjugated
50 μl, 100 μl, 200 μlHSD17B1 Rabbit Polyclonal Antibody [orb2952911]
ELISA, IHC, WB
Human
Rabbit
Polyclonal
Unconjugated
100 μg, 50 μg

Quality Guarantee
Explore bioreagents carefree to elevate your research. All our products are rigorously tested for performance. If a product does not perform as described on its datasheet, our scientific support team will provide expert troubleshooting, a prompt replacement, or a refund. For full details, please see our Terms & Conditions and Buying Guide. Contact us at support@biorbyt.com.

Immunohistochemical analysis of formalin-fixed paraffin embedded Rat Ovary Tissue using HSD17B1 antibody

Immunohistochemical analysis of formalin-fixed paraffin embedded Human Placenta Tissue using HSD17B1 antibody

Confocal immunofluoroscence analysis of HELA cells using HSD17B1 antibody

Western blot analysis of Lane 1: Rat Kidney Tissue Lysate, Lane 2: Rat Liver Tissue Lysate, Lane 3: 293T Cell Lysate, Lane 4: HELA Cell Lysate using HSD17B1 antibody

Immunohistochemical analysis of formalin-fixed paraffin embedded Rat Liver Tissue using HSD17B1 antibody
Quick Database Links
UniProt Details
−Documents Download
Request a Document
Protocol Information
Filter by Applications
Filter by Species
Yang, Yan et al. Directed mouse embryonic stem cells into leydig-like cells rescue testosterone-deficient male rats in vivo Stem Cells Dev, 24, 459-470 (2015)
Applications
Reactivity
Kozlowska, Wiktoria et al. Electromagnetic field exposure alters in vitro estrogen biosynthesis and its release by the porcine endometrium in the peri-implantation period Reprod Biol, 22, 100642 (2022)
Applications
Reactivity
HSD17B1 Rabbit Polyclonal Antibody (orb137855)
Participating in our Biorbyt product reviews program enables you to support fellow scientists by sharing your firsthand experience with our products.
Login to Submit a Review